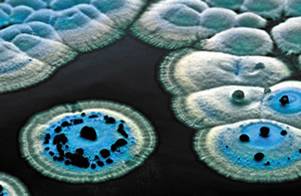

![]()
EL Mantillo y el Olor del Suelo Húmedo (Curso de Diagnóstico de Suelos en el Campo)
Es o debe ser la capa más superficial de un suelo (“Litter” en suahili), por lo que su falta puede deberse a erosión geológica o inducida por la acción humana. Está constituida por materia orgánica en proceso de descomposición. Es decir hojas, frutos, ramas y sus habitantes y excretas. Por lo tanto puede no ser propiamente parte del suelo, pero tiene varias funciones. Una de ellas es la de servir como cobertera al suelo para atenuar significativamente la evaporación del agua. Otra es servir como sustrato para la subsistencia de multitud de organismos, tanto microscópicos como macroscópicos. Las características de estos dependerán del tipo de material que lo constituye y el ambiente. Así las hojas de eucaliptos y pinos, limitan fuertemente la variedad de organismos que pueden aprovecharlas. En los climas cálidos y húmedos, la descomposición es muy rápida, sucede todo lo contrario en la tundra.

Los suelos cultivados generalmente no tienen mantillo, excepto en los terrenos en donde se practica la labranza nula (agricultura sin laboreo). La labranza y la fertilización aceleran la descomposición del mantillo y tarde o temprano, provocarán la disminución de la materia orgánica del horizonte superficial y por lo tanto de su fertilidad.
Cuando se integra al suelo, constituye lo que se conoce como materia orgánica del mismo, conocida por sus siglas en inglés como SOC y predomina en el horizonte A. Ahí además de formar parte del carbono secuestrado, desempeña una multitud de funciones tanto físicas y químicas, como biológicas. Se calcula que la materia orgánica aplicada a un suelo tarda unos cinco años para integrarse plenamente. Esto debe de tomarse en cuenta cuando se aplican abono y compostas.

Densa hojarasca de un bosque umbroso
Por otra parte el mantillo convencionalmente se clasifica según su grado de descomposición en:
Fíbrico al que lo es débilmente, hémico al moderadamente y sáprico aquel altamente descompuesto. Si en el fíbrico las características tales como es su forma, consistencia y aún el color de ramas, hojas y frutos, permanecen como si hubieran acabado de caer al suelo. En el mantillo sáprico dichas características ya desaparecieron totalmente, inclusive el color es oscuro y el olor es el clásico de la tierra.
Streptomyces coelicolor colonies. Fuente:
Opportunitie, the John Innes Centre.
From MicrobeWiki, the student-edited microbiology resource
Por cierto este último es generado por actinomicetos del género Streptomyces que tienen una amplia distribución los suelos del mundo. Resultan importantes en la descomposición aeróbica de los compuestos orgánicos y tienen un rol vital en el ciclo del carbono. Los productos de su metabolismo son llamados geosmins y le dan su olor carcterístico «a tierra«
Régulo León Arteta

[…] no visionado. Ya hablamos de este bichito filamentoso en nuestro post que versaba sobre el origen del olor del suelo húmedo. Lo que realmente aporta la minería consiste en la detección de metabolitos que no suelen estar […]
MUY BUENA LO QUE EXPONE ME GUSTARIA CONOCER MAS A CERCA DE CRIANZA DE LA LOMBRIZ PARA MEJORAR LA TIERRA. GRACIAS MIL
[…] hoy, no deja lugar a dudas. Resulta paradójico, por ejemplo, que esos microrganismos que dan olor del suelo se encuentren metidos dentro de esta ecuación cuando la basura humana, el estiércol y […]
trabajé algo de PPN…por lo que tuve que determinar la respiración edáfica en diferentes niveles…en medio boscoso…el lenguaje es afín…podría entrar a detalles de su actividad…que lo califica ..para definir el STRES o Strainer…Ecosistémico. de siempre corr.